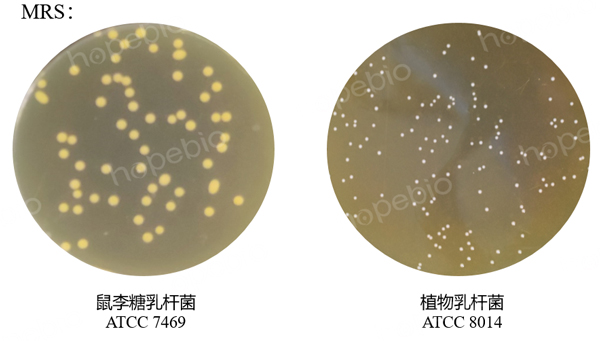

海博微信公众号
海博微信公众号
 海博天猫旗舰店
海博天猫旗舰店


 海博微信公众号
海博微信公众号
 海博天猫旗舰店
海博天猫旗舰店




一、产品介绍
主要用途:用于食品中乳酸菌的选择性增菌培养。
原理:蛋白胨、牛肉浸粉、酵母浸粉提供碳氮源、微生物和生长因子;磷酸氢二钾作为缓冲剂,维持培养基的pH;柠檬酸氢二胺可以螯合培养基中的金属离子,抑制某些杂菌的生长;乙酸钠抑制革兰氏阳性菌(非乳酸菌)的生长,创造有利于乳酸菌的选择环境;硫酸镁和硫酸锰参与酶的激活和细胞代谢;吐温80作为表面活性剂,促进乳酸菌对营养物质的吸收,同时有助于菌体分散。
二、培养基配方(g/L)
|
蛋白胨 |
10.00 |
|
牛肉浸粉 |
8.00 |
|
酵母浸粉 |
4.00 |
|
磷酸氢二钾 |
2.00 |
|
柠檬酸氢二胺 |
2.00 |
|
乙酸钠 |
5.00 |
|
硫酸镁 |
0.20 |
|
硫酸锰 |
0.04 |
|
吐温80 |
1.00 |
|
pH值5.7±0.2(25℃) |
|
三、试验方法
1、称取本品32.24g,加热溶解于1000mL蒸馏水中,分装于试管,118℃高压灭菌15min,备用。
2、以10倍梯度稀释法制备质控菌株菌悬液,吸取适宜梯度的菌悬液接种于待测培养基和参比培养基MRS。
3、放置于36℃需氧培养24h-48h。
四、结果观察
接种以下质控菌株,放置36℃需氧培养24h-48h,培养结果如图1所示。
|
质控菌株 |
菌株编号 |
接种量(CFU) |
参比或计数培养基 |
方法 |
质控结果 |
|
鼠李糖乳杆菌 |
ATCC 7469 |
10-100 |
MRS培养基 |
半定量 |
浑浊 |
|
植物乳杆菌 |
ATCC 8014 |
10-100 |
MRS培养基 |
半定量 |
浑浊 |
MRS肉汤(不含葡萄糖)

图1 MRS肉汤(不含葡萄糖)的微生物质控结果
五、知识扩展
1、发明者:MRS培养基的发明者是De Man、Rogosa和Sharpe。他们在1960年开发了该培养基,最初是为了替代成分不稳定的番茄汁培养基,同时为乳酸菌提供一种能使其旺盛生长的培养基。而MRS肉汤(不含葡萄糖)是由MRS培养改良过来的。
2、其他用途:
1)筛选非葡萄糖碳源利用菌株:去除葡萄糖后,仅保留蛋白胨、牛肉粉等复杂有机物作为潜在碳源,迫使乳酸菌利用非糖类物质生长,从而筛选出具有特殊碳源代谢能力的菌株。
2)研究碳源代谢调控通路:通过比较菌株在含/无葡萄糖培养基中的生长差异,结合转录组学分析,探究葡萄糖对乳酸菌代谢基因(如磷酸转移酶系统、糖酵解关键酶基因)的抑制效应(即“葡萄糖效应”)。
3、常见的改良配方及其应用
|
配方 |
修改内容 |
应用场景 |
|
添加莫匹罗星锂盐和半胱氨酸盐酸盐 |
莫匹罗星锂盐抑制除双歧杆菌外的其他乳酸菌的生长;半胱氨酸盐酸盐有利于厌氧菌的生长; |
|
|
添加葡萄糖和琼脂 |
用途最广的经典配方 |
|
|
添加莫匹罗星锂盐 |
莫匹罗星锂盐抑制除双歧杆菌外的其他乳酸菌的生长; |
|
|
主要添加麦芽糖和万古霉素 |
用于植物乳杆菌分离计数培养 |
六、小结
MRS系列培养基通过选择性抑制,成为乳酸菌分离培养和计数的核心工具之一,其各种改良配方进一步扩展了在特殊菌株检测中的应用。
相关产品
注:本文属海博生物原创,未经允许不得转载。
下一篇:没有了!
| 相关文章: | ||



